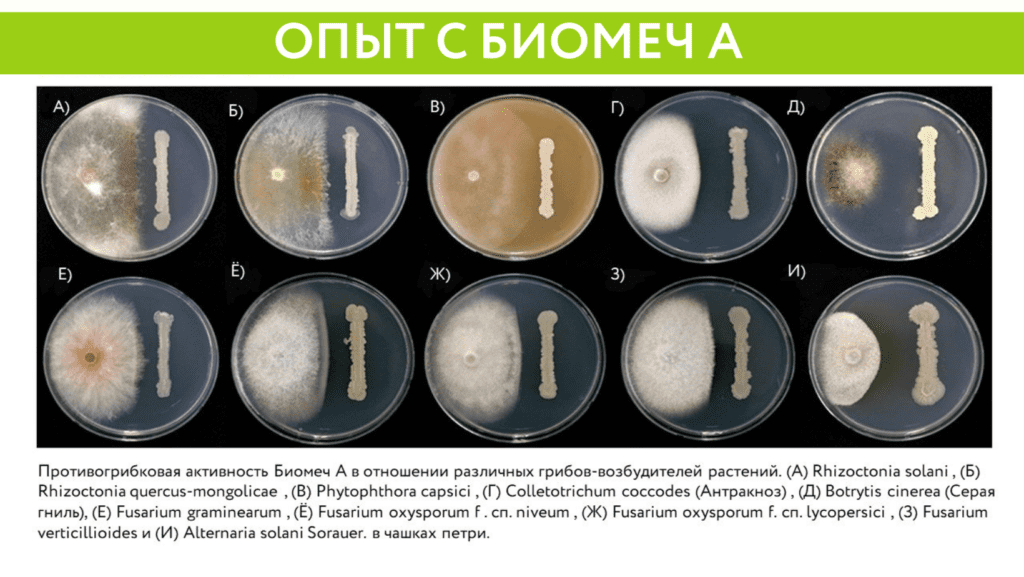
Опыт с Биомеч А (Azospirillum brasilence ОТ -22 -2%)

Фитотоксичность гормональных гербицидов на пшенице: риски применения в поздние фазы
На фото — проявления фитотоксичности на пшенице при позднем или повторном применении, а также при превышении норм расхода гормональных гербицидов...

Фитотоксичность гормональных гербицидов на пшенице: риски применения в поздние фазы
На фото — проявления фитотоксичности на пшенице при позднем или повторном применении, а также при превышении норм расхода гормональных гербицидов...

Новый биоинсектицид в портфеле: БиоМеч Инсекто. Применение и результаты испытаний
В нашем портфеле появилась новинка: биологический инсектицид БиоМеч Инсекто. В этой публикации мы покажем результаты предрегистрационных испытаний, а также расскажем...

Ложная мучнистая роса сои: как распознать и не потерять урожай
В условиях дождей, высокой влажности и слабой продуваемости в посевах сои резко возрастает риск появления ложной мучнистой росы (пероноспороза), возбудитель —...

Приствольная гербицидная защита сада — контроль сорняков на весь сезон
Содержать приствольную зону плодового сада в чистоте на каждом этапе вегетации — значит сохранить влагу, питательные вещества и здоровье деревьев....

Эффективная гербицидная стратегия в горохе: контроль сорняков как основа урожайности
Контроль сорняков — ключевой фактор в технологии возделывания гороха. Своевременное применение гербицидов позволяет снизить конкуренцию за свет, влагу и элементы...

Адъювант, который работает: как улучшить качество обработки полей
При внесении рабочих растворов пестицидов на целевые объекты часто возникают проблемы, влияющие на эффективность обработки. Среди наиболее распространённых: В портфеле...

Технология No-till: спасение сельского хозяйства или его провал?
Рассказывает менеджер технической экспертизыДобренко И. Е. No-till представляет собой современную технологию поддержки почвы, исключающую механическую вспашку и предусматривающую сохранение стерни...

Листовое питание сахарной свёклы: особенности применения
Обеспечение сахарной свёклы сбалансированным листовым питанием позволяет восполнить недостаток микроэлементов и частично защитить растение от неблагоприятных погодных условий. Ключевые особенности...

Почвенная инфекция – стратегия и тактика контроля
Рассказывает менеджер технической экспертизыДобренко И. Е. Стратегия контроля почвенной инфекции представляет собой комплекс мер, направленных на поддержание здоровья почвы и...

Возвратные заморозки: как защитить посевы и многолетние насаждения?
Весенние заморозки могут привести к значительным потерям урожая и повреждению растений. Особенно уязвимы культуры в стадии активного роста. Чтобы минимизировать...

Как улучшить эффективность препаратов: корректировка минерализации воды с помощью кондиционера Агропол Баланс
Даже самые качественные препараты могут не показывать максимальную эффективность, если вода, используемая для приготовления рабочих растворов, имеет высокую минерализацию. В...

Вьюнок в посевах зерновых культур — как с ним бороться
Для защиты поля от распространения вьюнка — предотвращения отрастания и уничтожения корневищ, рекомендуем до появления всходов культуры провести обработку молодых...

Как уберечь озимые зерновые от поражений грибами
Перед посевом озимых зерновых культур в каждом хозяйстве проводится тщательная обработка семян. Это важный агротехнический приём, направленный на предотвращение распространения...

Защита озимых зерновых культур от злаковой мухи в условиях засушливой осени
В большинстве регионов Южного федерального округа России сентябрь и октябрь 2024 года характеризовались сухой погодой, что привело к задержке посевной...

Универсал 5:23:35 Амино для питания озимых культур осенью
Сбалансированное фосфорно-калийное питание озимых культур осенью: самый простой способ помочь им подготовиться к зиме. Сегодня мы расскажем об одном из самых...

Повышаем эффективность десикации культур нашими десикантами Мегаполис, ВР и Полис, ВР
Для эффективной десикации посевов стратегических культур с использованием препаратов Мегаполис, ВР и Полис, ВР важно соблюдать нормы расхода, обеспечить качественное...

Борьба с широким спектром двудольных и злаковых сорняков в посевах сои
Основной проблемой на ранних стадиях развития сои (1-4 тройчатый лист) является смешанный спектр засорения посевов двудольными и злаковыми сорняками. Среди...

Система питания рапса
Для выбора интенсивности питания рапса при составлении схемы подкормок необходимо учитывать потенциальный урожай, зависящий от уровня влаги. Рекомендуется обращать внимание...

Питание сои «под ключ»
Питание сои начинается в период инокуляции семян. В это время семена подвергаются обработке биологическими препаратами на основе свободноживущих и симбиотических...

Стратегия гербицидной защиты картофеля
В борьбе с сорняками при выращивании картофеля используют два основных подхода: Заворовская (Гребневая) технология и Голландская промышленная система. Голландская промышленная...

Эффективная борьба с горчаком ползучим.
Горчак ползучий (Rhaponticum repens) — опасный, карантинный и трудноискоренимый сорняк. Его присутствие на поле чревато целым рядом проблем: Методы борьбы...

Система питания яблоневого сада интенсивного типа «под ключ»
Яблоневые сады интенсивного типа активно вытесняют экстенсивное садоводство в России, становясь более популярным направлением. Преимущества интенсивного типа очевидны: короткий срок...

Гербицидные обработки сахарной свёклы
Погодные условия в некоторых регионах не позволяют провести оптимально гербицидные обработки сахарной свёклы. Разрывы между обработками могут доходить до 15...

Эффективная борьба с падалицей подсолнечника в посевах зерновых культур
Падалица подсолнечника – проблемный сорняк для посевов зерновых. Она проявляет себя несколькими волнами, начиная с осени и продолжая весной. Для...

Исследование эффективности биопрепарата Фолимар, П
Посмотрите лабораторное исследование эффективности биопрепарата Фолимар, П (Bacillus amyloliquefaciens D 203, КОЕ/мл (1×10в 9 степени)) 0,1% водный раствор против фитофторы...

Эффективная работа с глифосатами
Использование глифосатов начинается с осени. Искореняющую обработку осуществляют в отношении многолетних корнеотпрысковых, а так же малолетних сорняков. Для этого на...

Готовим воду с помощью кондиционера Агропол Баланс
Подготовка проводится при высокой минерализации воды солями щелочных (Li, Na, K, Rb, Cs, Fr), щелочноземельных (Be, Mg, Са, St, Ba,...

Классификация протравителей
Протравители — это химические или биологические продукты, применяемые для протравливания семенного и посадочного материала с целью защиты зародыша и будущих...

Особенности применения комплексных удобрений
Сегодня на рынке существует большое количество марок комплексных удобрений для листового питания, требования и рекомендации к применению которых часто противоречат...
Опыт с Биомеч А (Azospirillum brasilence ОТ -22 -2%)
Биомеч А (Azospirillum brasilence ОТ -22 -2%) — микробиологический продукт, выступающий в качестве свободноживущего азотофиксатора почвы. Предназначен для инокуляции посевного...

Агрохимическая классификация элементов.
Линейка удобрений Фолирус от Листерра сегодня представлена 48-ю марками, а в ближайшее время появятся новые. Давайте сегодня разберёмся в классификации...

Обзор демонстрационных испытаний системы защиты сои в ПФО Зерновой Соевый Союз
Обзор демонстрационных испытаний системы защиты сои ЭФФЕКТИВНОСТЬ ПРИМЕНЕНИЯ СИСТЕМ ЗАЩИТЫ СОИ (БОГАРА) Продукты-участники демонстрационных испытаний Применение почвенных гербицидов на сое...

Как работает Агропол от Листерра
Агропол — поверхностно-активный адъювант (прилипатель). Применяется в рабочих растворах пестицидов и агрохимикатов для повышения их биологической активности и увеличения срока...

Тестирование Агропол Баланс

Три ключа к «Отличному старту» озимой пшеницы
На YouTube канале компании вышло новое видео, где наша уникальная виртуальная помощница Флора, вдохновлённая экспертами компании Листерра, поделилась секретами успешного...

Ржавчина подсолнечника (Puccinia helianthi Schwein.) в стадии спермогоний и эций.
Ржавчина подсолнечника является одним из наиболее разрушительных грибных заболеваний, поражающих подсолнечник во многих странах мира. В стадии спермогоний на обратной...

Отзыв о работе с препаратами LYSTERRA
Наши препараты проверены опытными фермерами. Отзыв одного из них в видеоматериале ниже.
Что-то пошло не так...
Данные успешно отправлены.
Ценим Ваше доверие.
Мы используем cookies для аналитики и улучшения работы сайта.
Подробнее — в Политике cookies и Политике конфиденциальности